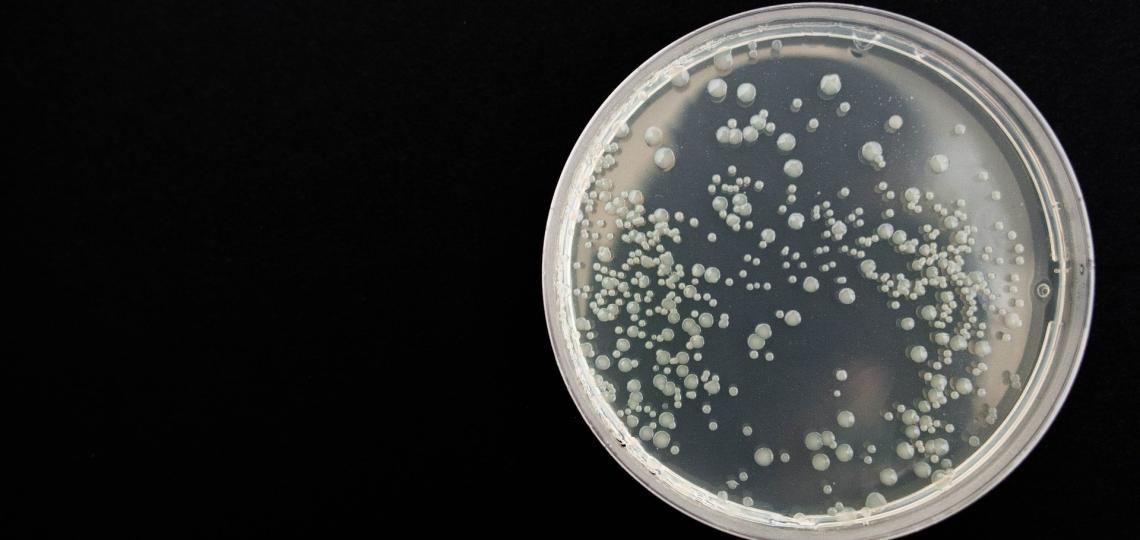
Bacteria

Novel approach identifies genes linked to autism and predicts patient IQ
According to some estimates, hundreds of genes may be associated with autism spectrum disorders (ASD), but it has been difficult to determine which mutations are truly involved in the disease and which are incidental. New work published in the journal Science Translational Medicine led by researchers at Baylor College of Medicine shows that a novel computational approach can effectively identify genes most likely linked to the condition, as well as predict the severity of intellectual disability in patients with ASD using only rare mutations in genes beyond those already associated with the syndrome.
Knowing which genes contribute to ASD, researchers can then study them to better understand how the condition happens and use them to improve predicting the risk of the syndrome and more effectively advise parents of potential outcomes and treatments.
“ASD is a very complex condition and many cases do not have a clear genetic explanation based on current knowledge,” said first author Dr. Amanda Koire, a graduate student in the Dr. Olivier Lichtarge lab during the development of this project. She is currently a psychiatry research resident at Brigham and Women’s Hospital, Harvard Medical School.
There is not one gene that causes the majority of ASD cases, the researchers explained. “The most commonly mutated genes linked to the syndrome only account for approximately 2% of the cases,” said Lichtarge, Cullen Chair and professor of molecular and human genetics, biochemistry and molecular biology and pharmacology and chemical biology at Baylor. “The current thought is that the syndrome results from a very large number of gene mutations, each mutation having a mild effect.”
The challenge is to identify which gene mutations are indeed involved in the condition, but because the variants that contribute to the development of ASD are individually rare, a patient by patient approach to identify them would likely not succeed. Even current studies that compare whole populations of affected individuals and unaffected parents and siblings find genes that only explain a fraction of the cases.
The Baylor group decided to take a completely different perspective. First, they added a vast amount of evolutionary data to their analyses. These data provided an extensive and open, but rarely fully accessed, record of the role of mutations on protein evolution, and, by extension, on the impact of human variants on protein function. With this in hand, the researchers could focus on the mutations most likely to be harmful. Two other steps then further narrowed the resolution of the study. A focus on personal mutations, that are unique to each individual, and also on how these mutations add up in each molecular pathway.
Exploring the contribution of de novo missense mutations in ASD
The researchers looked into a group of mutations known as missense variants. While some mutations disrupt the structure of proteins so severely as to render them inactive, missense mutations are much more common but are harder to assess than loss-of-function mutations because they can just tweak the protein’s function a little or severely impair it.
“Some loss-of-function mutations have been associated with the severity of ASD, measured by diminished motor skills and IQ, but missense mutations had not been linked to the same ASD patient characteristics on a large-scale due to the difficulty in interpreting their impact,” said co-author Dr. Panagiotis Katsonis, assistant professor of molecular and human genetics at Baylor. “However, people with ASD are more likely to carry a de novo missense mutation than a de novo loss-of-function mutation and the tools previously developed in our lab can help with the interpretation of this majority of coding variants. De novo or new mutations are those that appear for the first time in a family member, they are not inherited from either parent.”
The researchers took on the challenge to identify, among all the de novo missense mutations in a cohort of patients with ASD and their siblings as a whole, those mutations that would distinguish between the patients and the unaffected siblings.
A multilayered approach
The team applied a multilayered strategy to identify a group of genes and mutations that most likely was involved in causing ASD.
They first identified a group of de novo mutations by examining the sequences of all the protein coding genes of 2,392 families with members with ASD that are in the Simons Simplex Collection. Then, they evaluated the effect of each missense mutation on the fitness or functionality of the corresponding protein using the Evolutionary Action (EA) equation, a computational tool previously developed in the Lichtarge lab. The EA equation provides a score, from 0 to 100, that reflects the effect of the mutation on the fitness of the protein. The higher the score, the lower the fitness of the mutated protein.
The results suggested that among the 1,418 de novo missense mutations affecting 1,269 genes in the patient group, most genes were mutated only once.
“Knowing that ASD is a multigenic condition that presents on a spectrum, we reasoned that the mutations that were contributing to ASD could dispersed amongst the genes of a metabolic pathway when examined at a cohort level, rather than being clustered on a single gene,” Koire said. “If any single component of a pathway becomes affected by a rare mutation, it could produce a clinical manifestation of ASD, with slightly different results depending on the specific mutation and the gene.”
Without making any a priori assumptions regarding which genes or pathways drive ASD, the researchers looked at the cohort as a whole and asked, in which pathways are there more de novo missense mutations with higher EA scores than expected?
The team found that significantly higher EA scores of grouped de novo missense mutations implicated 398 genes from 23 pathways. For example, they found that axonogenesis, a pathway for the development of new axons in neurons in the brain, stood out among other pathways because it clearly had many missense mutations that together demonstrated a significant bias toward high EA scores indicating impactful mutations. Synaptic transmission and other neurodevelopmental pathways were also among those affected by mutations with high EA scores.
“As a result of layering together all these different complementary views of potential functional impact of the mutations on the biology, we could identify a set of genes that clearly related to ASD,” Lichtarge said. “These genes fell in pathways that were not necessarily surprising, but reassuringly related to neurological function. Some of these genes had been linked to ASD before, but others had not been previously associated with the syndrome.”
“We also were very excited to see a relationship between the EA score of the mutations in those genes linked to ASD and the patient’s IQ,” Koire said. “For the new genes we found linked to ASD, the mutations with higher EA scores were related to a 7 point lower IQ in the patients, which suggests that they have a genuine biological effect.”
“This opens doors on many fronts,” said co-author Young Won Kim, graduate student in Baylor’s Integrative Molecular and Biomedical Sciences Graduate Program working in the Lichtarge lab at the time of research. “It suggests new genes we can study in ASD, and that there is a path forward to advise parents of children with these mutations of the potential outcomes in their child and how to best involve external support in early development intervention, which has shown to make a huge difference in outcome as well.”
“Our findings may go beyond ASD,” Lichtarge said. “This approach, we hope, could be tested in a wide set of complex diseases. As many genome sequence data become increasingly accessible for research, it should then be possible to interpret the rare mutations which they yield as we showed here. This may then resolve better than now the polygenic basis of various adult diseases and also improve estimates of individual risk and morbidity.”
Christie Buchovecky, at Baylor and Columbia University, and Stephen J. Wilson at Baylor also contributed to this work.
This work was supported by the National Institutes of Health (grant numbers GM079656-8, DE025181, GM066099, AG061105), the Oskar Fischer Foundation, the National Science Foundation (grant number DBI1356569) and the Defense Advance Research Project Agency (grant number N66001-15-C-4042). In addition, this study received support from RP160283 - Baylor College of Medicine Comprehensive Cancer Training Program, the Baylor Research Advocates for Student Scientists (BRASS), and the McNair MD/PhD Scholars program.